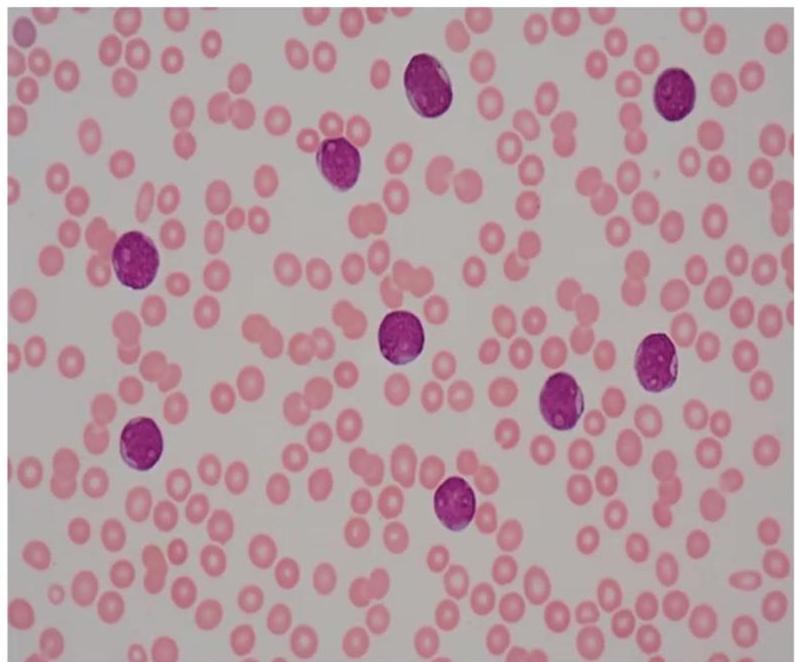
img-347.jpeg|232x212
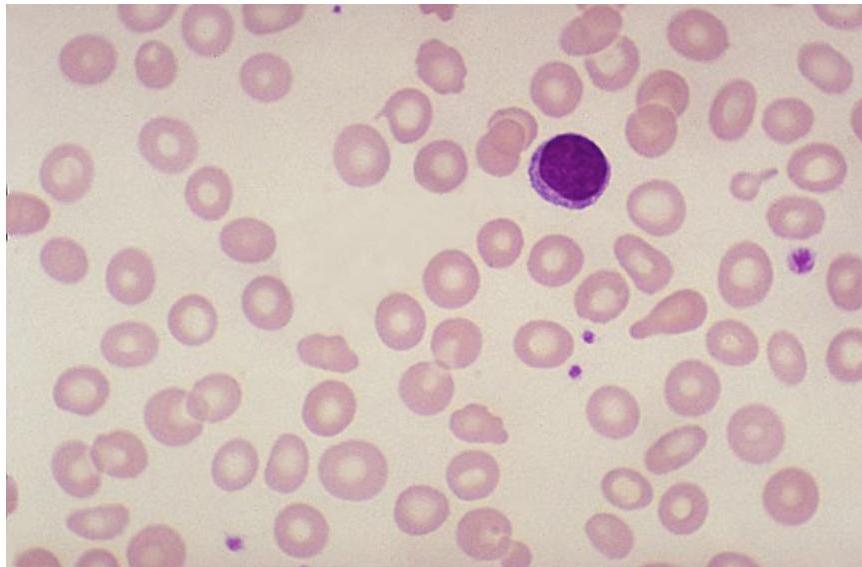
img-175.jpeg|358x235

PEDIA-OSPE
EEG
If 3 spikes in 1 second - petite mal epilepsy i.e. absence seizure

Hibs HYBS? arrhythmia - tubelous sclerosis y
 EEG, hypsarrhythmia, infantile spasms, and tuberous sclerosis complex (TSC)
Â


Cerebral Palsy Types
Spastic CP (Scissoring legs):
- Large ears
- Muscle wasting
- Fisting in hands (resistive hand posture)
- Nystagmus
- History of severe birth asphyxia
This child has a history of severe Birth Asphyxia.What are your neurological diagnoses?
- Severe microcephaly (brain atrophy)
- Severe spastic quadriplegic cerebral palsy


Case about a child who’s drooling no important data other than the drooling as far as i remember.
Q1: what’s the diagnosis? A: dyskinetic cerebral palsy.
Q2: what’s the origin? A: extrapyramidal.
Dystonic cerebral palsy or dyskinetic or choreoathetoid cerebral palsy
Findings:
- Involuntary muscle spasms and unwanted movement
- Poor saliva control
- Drooling
Origin:
- Extrapyramidal involvement
IQ:
- Normal
Fisting (Persistence >6-8 weeks)

When should disappear in normal child?
- 6-8 weeks of birth
Persistence at 12 months indicates:
- Cerebral palsy
- Edward syndrome
Neurology & Neonatology
MRI Findings in Hypotonia

Modality: MRI
Findings:
- Absent corpus callosum
- Asymmetrical ventricles
- Brain atrophy
- Brain central edema
Type of Hypotonia:
- Central hypotonia
Hypotonia Types
Central Hypotonia

Findings:
- Rigid joints
- Long neck
- Long tongue
- Thick lips
- Rigid joint, long neck, long tongue, thick lips
- Central hypotonia
Diagnosis:
- Screen for Mucopolysaccharidosis type 2 (Hunter syndrome) x-linked
Other Causes:
- Cerebral palsy
- Brain damage due to HIE
- Muscular dystrophy
Axial Hypotonia
2 month old baby is examined in the clinic Tests:
- Ventral suspension test (inverted U shape)
- Pull to sit test (head lag)
Findings:
- U-shaped on ventral suspension
- Floppy child
- Head lag on pull to sit test
Causes:
- Down syndrome
- Cerebral palsy
- Muscular dystrophies
How do you expect the power?
- Reduced.

U shaped


Peripheral Hypotonia
This is a hypotonic infant with Fasciculations in the tongue.


Findings:
- Deformed chest
- Alert baby
- Fasciculations of tongue
- Reduced power
- “Two hands up” posture (often intubated)
- Causes of hypotonia?
- cerebral palsy
- brain damage due to HIE
- muscular dystrophy
Diagnosis:
- Spinal muscular atrophy type 1 (Hoffman disease) =] - If there Peripheral hypotonia +Fasciculations of tongue?
- Frog leg position
Infant Position:
- Frog position
- Hypotonia
- Alert and simple
This is a hypotonic infant, how do you expect the power?
- Reduced
Spina Bifida / Myelomeningocele


Findings:
- Sunset eye
- Big head
- Dilated veins in head (sign of increased ICP)
Most common cause of hydrocephalus:
- Myelomeningocele
Next to examine:
- Back
- Check pulse and BP (increased ICP) Treatment:
- Closure of myelomeningocele
- VP shunt
sunset eye with hydrocephalus, given vp shunt

Blueberry Muffin Rash

Associated with:
- Hepatosplenomegaly
Main Causes:
- CMV
- Toxoplasmosis
- Acute neoplastic leukemia (e.g., congenital leukemia)
Differentiation from Meningococcemia:
- Newborn with skin rash and hepatosplenomegaly
- Type of rash: Blueberry muffin rash
- Not meningococcemia because there is hepatosplenomegaly
CMV Infection


year old girl has had recurrent episodes of swelling of her hand and feet for last 6 month, these 12 episodes occur following exercise and emotional stress last for 2-3 days and resolve spontaneously. The last episode was accompanied abdominal pain, vomiting and diarrhea the results of routine laboratory workup are normal an older sister and a maternal uncle have had similar episodes as shown in photographs below
Diagnosis? CMV.
CT finding? Periventricular calcification (vs Toxo which is scattered).
Findings:
- Microcephaly
- Jaundice
- Hearing loss
- Non-blanching rash
- Small for gestational age
- Calcification around the ventricles (C-shape)
Memory aid:
- C-shape calcification = CMV
Congenital Toxoplasmosis




This child was delivered with jaundice, HSM, wide spread rashes and progressive head enlarging. Mather gave history of contact with cats early in her pregnancy.
- Diagnosis?
- Congenital Toxoplasmosis “Lipic Vaginal” (Lipic Vaginal), - differential - CMV (paraventricular first image - c shaped)
Findings:
- Jaundice
- Hepatosplenomegaly
- Widespread rashes
- Progressive head enlargement
- Mother history of contact with cats early in pregnancy
Investigation? Serology (IgM and IgG).
CT Finding: Intracranial calcification (extensive cerebral calcifications) — scattered pattern.
- CNS calcifications (tram calcification pattern)
- Calcification in the border called “tram calcification”
- CMV has calcification around the ventricles (C-shape)
Hypoxic Ischemic Encephalopathy (HIE)
Therapeutic Hypothermia



Scenario: One day old baby with severe HIE - Full term newborn admitted to NICU due to severe birth asphyxia (hypoxic ischemic encephalopathy).
Q1: What is the mode of therapy?
- Therapeutic hypothermia Head-selective (or whole body) therapeutic hypothermia (e.g., Olympic Cool Cap).)
- Temperature: 33.5-34.5°C,
- Duration: started within 6 hours, used for 48 hours - 2-3 days
Q2: What is the effect of this therapy?
- Neuroprotection
- Decrease brain injury
- Reduce energy requirements and level of free radicals
- Preserves anti-oxidants
- Inhibit apoptosis
- Reduce damage caused by 2nd stage
Indications:
- Severe birth asphyxia
HIE Complications
A 10 days old infant, suffered a moderate severe HIE from which he recovered. He showed spastic posture, What is the abnormality seen in his face?
Facial Palsy:

Diagnosis:
- Facial palsy (right sided)
- LMN (Whole face affected)
Other features of HIE:
- Fisting
- Extension of hip
- Flexion of knee
- Dorsiflexion of feet
Complications of HIE:
- Acute renal failure
- Myocardial dysfunction
- Coagulation impairment
Horner’s syndrome, partial ptosis
Sympathetic distrubtion
- cervical; Parasympathetic
- thoracic; Sympathetic
- lumbar; Sympathetic
- sacral; Parasympathetic
6th, 7th 12th cranial palsy.

Neurofibromatosis Type 1

iris hemarto…
Pedigree:
- Mode of inheritance: Autosomal Dominant
Clinical Findings:
- Café-au-lait spots
- Lisch nodules in eyes (seen via slit lamp)
Hypopigmented Area - ashleaf tuberous sclerosis

- May indicate magnesium deficiency?? C
Nodule in Rash

Diagnosis:
- Tuberculosis??? C
Tuberous Sclerosis -
adenoma sebacome


Findings:
- Adenoma sebaceum
- Shagreen patch
- Ash leaf spots (white spots - differential includes Vitiligo)
- Alopecia patch on head (Benqueth/Sanders syndrome)
Sturge-Weber Syndrome

Findings:
- Port-wine stain in the face
- Seizures
- Tram-like intracerebral calcifications (usually same side as the stain)
Complications:
- Seizures (focal epilepsy, usually opposite side of the brain calcifications)
- Glaucoma
Incontinentia Pigmenti
- Finding: A recognized neurocutaneous syndrome presenting with distinctive skin rashes along Blaschko’s lines, alopecia, and neurological symptoms.
Wilson Disease



Slit lamp examination for diagnostics
Diagnosis? Wilson Disease.
Clinical Signs: Kayser-Fleischer ring in the cornea.
Management? D-penicillamine (copper chelation), zinc supplementation, low copper diet.
IUGR (Intrauterine Growth Restriction)

Scenario: Infant delivered by C/S due to fetal distress at 40 weeks, birth weight 2.1 kg, severe difficult-to-control hypoglycemia.
Diagnosis:
- IUGR
Maternal Causes:
- Smoker
- Poor nutrition
- Maternal hypertension
Pathological Causes:
- Trisomy 21
- CMV infection
- Congenital heart disease
Complications:
- Hypothermia
- Hypocalcemia
- Hypoglycemia
- Low Apgar score
- Intraventricular Hemorrhage (IVH)
Long-term Complications:
- Lower IQ
- Cerebral palsy
- Mental retardation
Growth Charts
Types of Failure to Thrive
Recurrent FTT (Child Abuse)

Type:
- Birth up to 36 months
- Length for age and weight for age percentile
Description:
- Both weight and length lines cross 2 centile chart twice
Diagnosis? Child abuse (recurrent failure to thrive, untreated).
Celiac Disease (FTT Pattern)

Description:
- Weight and length from birth to age 36 months
- Deceleration of growth apparent at age 9 months
Diagnosis:
- Gluten sensitivity disease (Celiac)
Next Investigation:
- Endomysial antibodies
Congenital Abnormality Pattern

Findings:
- Both weight, height, and head circumference decreased
- Due to congenital abnormality
Recurrent FTT Pattern


Description:
- Girl: Normal start → FTT → improved → FTT again
- Pink chart for girls
- Both height and weight cross 2 percentile downward twice
Diagnosis:
- Recurrent failure to thrive
Causes:
- Child abuse
- Malabsorption (e.g., celiac disease)
Intermittent FTT Pattern

Description:
- Girl’s growth chart showing intermittent failure to thrive
IUGR Pattern

Description:
- Boy showing FTT, both weight and height affected
- Eventually improved (maybe due to IUGR)
Mucopolysaccharidosis (MPS) -
Hurler Syndrome (Type 1 Mucopolysaccharidosis) Z
Metabolic storage diseases; often presents with central hypotonia. Hurler (Autosomal Recessive)
- A rare lysosomal storage disease
- Skeletal abnormalities, cognitive impairment, heart disease, respiratory problems, enlarged liver and spleen
- Characteristic facies
- Absence of alpha-L-iduronidase enzyme, responsible for degradation of MPS
- Build up of dermatan sulfate and heparin sulfate in multiple tissues, resulting in progressive deterioration and, eventually, death

Infant of Diabetic Mother (IDM)


Macrosomia, Red, Polycythemia, with erbs palsy - infant of diabetic mother. persistant primitive reflect, stiff, probable for CP
mother hypoglycemic, cause permament damage to the infant - pamcreas enlargement, sequele to oversecretion insulin leading to…
- This infant suffered of severe hypoglycemia and hypocalcemia. His mother had no antenatal care.
- What is your diagnosis?
- Large for GA, Infant of diabetic mother (macrosomia)
Findings:
- Large for GA
- Severe hypoglycemia
- Hypocalcemia
Complications:
- Respiratory distress
- Polycythemia
- Congenital malformations
Metabolic Complications:
- Hypocalcemia (Check Calcium and Magnesium)
- Hypoglycemia
- Hypomagnesemia
- Polycythemia
Congenital Malformations & Injuries:
- ASD, VSD, TOF, TGA
- Sacral agenesis
- Erb’s palsy
- Cystic hygroma
Beckwith-Wiedemann Syndrome
This baby has facial dysmorphism, macroglossia, nevus flammeus, and omphalocele. His birth weight was 4.9 kg, and he developed severe hypoglycemia soon after birth.
Findings:
- Omphalocele
- Macroglossia
- Nevus flammeus
- Birth weight 4.9 kg (macrosomia)
- Severe hypoglycemia soon after birth
Diagnosis:
- Beckwith-Wiedemann syndrome
Congenital Infections (TORCH)
Congenital Hypothyroidism

Lab Findings:
- Elevated TSH
Findings:
- Developmental delay
- Constipation
Complication:
- Mental retardation
Lipoatrophy

Scenario: 13-year-old diabetic girl for follow-up. HgA1c is 6.5, random blood glucose 260mg/dl
Finding:
- Lipoatrophy at injection sites
Risk Factors:
- DM
- Hypothyroidism
- PCOS
Hashimoto Thyroiditis

Findings:
- DM1 patient (Autoimmune polyendocrine syndrome)
- Goiter
Investigations:
- TSH, FT4, FT3
- Thyroid antibodies (anti-TPO, anti-Tg)
Acanthosis Nigricans




Causes/Conditions:
- Type 2 diabetes
- Cushing disease (and other adrenal gland issues)
- PCOS
- Pituitary disorders
- Hypothyroidism
- High doses of niacin
Investigations:
- Fasting blood sugar
- HgA1C
Cushing Syndrome

Scenario: This boy presented with short stature, his hight below 3rd percentile, hid weight above 95th percentile..what is the most likely cause?
Diagnosis:
- Cushing syndrome
Galactosemia


Scenario: 3 month old with hepatosplenomegaly, hypoglycemia, decreased tone and muscle strength. Older brother on special milk formula.
Clinical sign? Bilateral cataracts.
Diagnosis? Galactosemia.
Leukocoria (Retinoblastoma)


Finding:
- White reflex in the pupil (leukocoria)
- Cat’s eye reflex
Diagnosis:
- Retinoblastoma
Infective Endocarditis
Signs:
- Janeway lesions: Painless, hemorrhagic, flat plaques on palms and soles (septic emboli)
- Osler’s nodes: Painful, reddish, raised nodules on finger pads/toes (immune complex deposits)
Cause:
- Streptococcus viridans
Management:
- Penicillin and gentamicin
Investigation:
- Echocardiogram


Herpes Zoster (Shingles)


Scenario: 8 years old boy had severe facial pain, 2 days later skin rash appeared in the same area
Q1: What is the cause?
- Varicella-zoster virus
Q2: What is the diagnosis?
- Herpes zoster (shingles)
Q3: What are the clues?
- ½ face involvement
- Pustules
- Secondary bacterial infection
Management:
- Acyclovir
- Pain killer
- Antihistamine
- Antibiotic (if secondary infection)
Chickenpox (Varicella)


Type of rash: Vesiculopapular
Complications:
- Secondary skin infections
- Sepsis
- Encephalitis
- Microcephaly
- Hydrocephaly
- Cataracts
- Chorioretinitis
- Absent deep tendon reflexes
- Horner’s syndrome
- Hypopigmentation
- Most common: Aseptic meningitis
Hemorrhagic Chickenpox

Make sure its not immune deficiency
Shingles reactivation


Herpetic Gingivostomatitis
3 years old child presented with fever and refusal to eat, your examination showed


- Diagnosis ?
- Herpes simplex 1 (herpetic gingivostomatitis)
Finding:
- Aphthous ulcers
- Oral mucosa ulceration
Treatment:
- Acyclovir gel
- Severe cases: IV acyclovir
Herpes Simplex (Herpetic Labialis)

Finding:
- Cluster of vesicles below the lower lip (Herpetic)
Diagnosis:
- Herpes labialis (Herpes simplex type 1)
transmission
Herpetic Whitlow
Findings:
- HSV-1 infection on the finger (whitlow)
Management:
- Topical acyclovir
Acute Lymphoblastic Leukemia (ALL)

Scenario: 4-year-old boy with fever, hepatosplenomegaly
Abnormality in peripheral smear? Blast cells (lymphoblasts).
Diagnosis? Acute Lymphoblastic Leukemia (ALL).
Other Signs:
- Anemia signs: dizziness, pallor
- Thrombocytopenia: petechiae, purpura
- Recurrent infections
- Bone pain
- Weight loss
- Hepatosplenomegaly
Bone Marrow:
- Single cell blast
Confirmatory Investigations:
- Bone marrow aspiration and biopsy
- Immunohistochemistry
Treatment:
- Chemotherapy
- Supportive measures
Prognosis?
- Good prognosis if treated — children are cured in 90%
- Males treated for 3 years, females treated for 2 years
Findings: Leukemic morphology, cant diagnosis what type - however AURE ROD findings
would most likely point to AML
Pyloric Stenosis


Scenario: weeks old male infant presented with projectile vomiting after feeding progressively worse, non bilious, no fever, no diarrhea, less active than before
Clinical Findings:
- Signs of dehydration. Z
- Abdominal distension
- Visible peristalsis
- Inverted umbilicus
- Olive sign in epigastrium
Diagnosis:
- Infantile hypertrophic pyloric stenosis / Congenital pyloric stenosis
Complications:
- Hypochloremic hypokalemic metabolic alkalosis
- Severe dehydration
Mode of Inheritance:
- Autosomal Dominant
Management:
- Fluid resuscitation
- Potassium chloride and electrolyte correction
- Surgical treatment (pyloromyotomy)
Toxicology & Emergencies
Corrosive Poisoning / Esophageal Stricture

Scenario: 3 year old poisoned at home with severe acute injury and long-term complications.
Poison type? Corrosive (bleach, disinfectants, detergents, cleaning agents).
Barium swallow finding? Esophageal stricture.
Corrosive Poisoning


Scenario: Toddler reached chemicals area OR 15-month-old with corrosive ingestion
Findings:
- Drooling saliva
- Lip ulcer
- Redness in right eye
- NGT in place
Question: What type of poisoning?
- Corrosive poisoning
Contraindicated Measures:
- Induction of emesis
- Gastric lavage
- Administration of activated charcoal
- Neutralizing substances with weak acid/base
Management:
- IV Fluids and antibiotics
- Endoscopy within 48 hours
Long-term Complication:
- Esophageal stricture
Henoch-Schönlein Purpura / IgA Vasculitis (HSP)









Scenario: 11-year-old female with abdominal pain, joint pain, new skin rash. Stool positive for occult blood. - 10 year old boy with purpuric skin rash and adbdominal pain what is most likely diagnosis? mention 2 complication - 8-year-old boy with joint and abdominal pain.
Rash Description:
- Purpuric rash at buttock and extensor arms
- Palpable purpura
Diagnosis:
- Henoch-Schönlein purpura (HSP)
- Part of IgA nephropathy
Complications:
- Renal involvement (hematuria, proteinuria, chronic kidney disease, hypertension)
- Intussusception
- Encephalopathy
- Massive GI bleeding
- Acute glomerular lesion
- In boys: scrotal edema and testicular torsion
Systemic Juvenile Rheumatoid Arthritis (Still’s Disease)



Keywords:
- Spiking fever
- Rash started in the trunk
- Growth affected (chronic condition)
Rash Type:
- Salmon-colored rash
- Fades with pressure
Diagnosis:
- Systemic juvenile rheumatoid arthritis (Still’s disease)
Juvenile Rheumatoid Arthritis (JRA)



5 years old girl who has been limping with swelling of her right knee for several months, parents note that she cannot fully extend her right knee. She does not want to walk in the morning, but seems fine later in the morning and the rest of the day. Left knee swelling is noticed for last 3 weeks.
Chronic Arthropathy Findings:
- Knee swelling
- Hand defects/deformities
- Wasting of thigh muscles (indicates chronic condition)
- No redness (indicates chronic vs acute)
Differential Diagnosis:
- Juvenile rheumatoid arthritis (JRA)
- SLE
- Hemarthrosis (in hemophilia)
- transient synovitis?septic arthritis?bruccelosis?
Scenario: 7-year-old child with limping
Abnormalities:
- Deformity in both knees
- Swelling in right knee
- Muscle wasting
Causes:
- JRA
- Hemarthrosis due to hemophilia
Management objectives:
- Promote normal growth and development.
- Factor 8 (for hemophilia)
- Aspiration and antibiotics (for septic arthritis)
if septic
If fever and red swelling knee, rule out first:
- Septic arthritis
Organism: if septic arthritis
- Staphylococcus
Neonatal Infection

Scenario: CBC of 2-day-old baby who looked ill, tachypneic and distressed
CBC Findings:
- Mature neutrophilia
- Band cells
- Toxic granulation
Diagnosis:
- Neonatal infection (Sepsis)
Next Investigations:
- Blood culture
- CRP
- Serum lactate
- U/E
- Screening swab
Hemangioma

Diagnosis:
- Capillary (Strawberry) Hemangioma
Management:
- Observation (often involute)
- Propranolol
- Systemic or intralesional steroids
- Laser therapy
Neonatal Lupus



Scenario: 3-month-old anti-Ro/SSA positive male infant OR 2-month-old anti-Ro/SSA positive male infant
Findings:
- Discoid rash
- Photosensitivity
- Skin rash and low pH
- Mother with facial rash occasionally pruritic
Diagnosis:
- Neonatal SLE / Neonatal lupus / Neonatal lupus erythematosus.
Other Manifestations:
- Malar rash (neck redness)
- Complete heart block
- Hepatomegaly (hepatitis)
- Anemia
- Thrombocytopenia (bruise)
- Oral ulcer
- Arthritis
Cardiac Complication:
- Heart block
Photosensitivity

Finding:
- Photosensitivity of SLE (Area not covered)
Hereditary Angioedema

Scenario: Girl with recurrent episodes of swelling of hands and feet for 6 months (12 episodes), following exercise and emotional stress, lasting 2-3 days. Last episode with abdominal pain, vomiting, diarrhea. Family history: older sister and maternal uncle with similar episodes.
Diagnosis:
- Hereditary angioedema
Periorbital Edema




Findings:
- Periorbital edema secondary to fluid overload (mild cases)
- Very severe facial edema secondary to hypoalbuminemia (severe cases)
Causes of Generalized Edema:
- Fluid overload (mild edema): Renal failure, heart failure
- Hypoalbuminemia (severe edema): Kwashiorkor, chronic liver disease, nephrotic syndrome, protein losing enteropathy
Causes:
- Nephrotic syndrome
- Liver disease
- Heart failure
- Anaphylactic shock
- Angioedema
Hematology & Oncology
Hemolytic Uremic Syndrome (HUS)


Scenario:
- Patient with bloody diarrhea, fever, weakness, periorbital edema
- Developed acute renal failure, microangiopathic hemolytic anemia, thrombocytopenia
Peripheral Blood Smear:
- Abnormal shape of RBCs (fragmented RBCs/schistocytes)
- Thrombocytopenia
Diagnosis:
- Hemolytic-uremic syndrome
Triad:
- Renal failure
- Anemia
- Thrombocytopenia
Signs:
- Bloody diarrhea
- Vomiting
- Petechiae
- Oliguria
- Dehydration
- Hypertension
- Seizure
Causes:
- E. coli O157:H7
- Shiga toxin
Management (supportive):
- Hydration/Fluid replacement
- Managing complications of renal failure (dialysis, HTN control)
- Blood transfusion
Skin Lesions from Child Abuse
Sock-glove burn: & Cigarette Burns

Pattern:
- Sock-glove like burns
- Multiple rounded scars (cautery marks)
Seen when:
- Feet or hands held in water
- Line of demarcation suggests non-accidental injury
Diagnosis:
- Child abuse
Rib Fracture

Finding:
- Rib fracture
- Healed fracture
Diagnosis:
- Child abuse
Immersion Burns

Scenario: 2 year old with symmetrical burns on both hands and feet, brought to ER.
Burn pattern? Thermal injuries with stocking-and-glove distribution (immersion injuries).
Accidental? FALSE — this is child abuse.
Electrical Injury


Diagnosis:
- Child abuse
- Type: Neglect
Prevention:
- Place baby in crib
- Baby sitter
Raccoon Eyes

Scenario: This boy presented with history of partial seizure. What will be your next step after history and examination?
Finding:
- Periorbital ecchymosis (raccoon eyes)
Diagnosis:
- Child abuse (basilar skull fracture)
Elbow burn (delayed presentation):

Baby Shaken Syndrome


Scenario: 4-month girl presents to ED with recurrent vomiting, admitted, discharged stable (seen at hospital twice before), 5 days later presents with unresponsive episode, bulging fontanelles (listlessness) to PICU.
Findings:
- Subdural hemorrhage
Diagnsois?
- baby shaken syndrome
Complications:
- Cerebral edema
- Retinal hemorrhage
Scenario: 9-month-old infant with skin lesions and irritability due to native remedy
Findings:
- Multiple cautery marks (traditional treatment)
Q1: What is the cause of lesions?
- Due to multiple cautery marks
Q2: What are complications?
- Infection
- Sepsis
- Scarring

Physical Abuse - Cautery Marks


Findings:
- Multiple rounded scars (cautery marks) in abdomen and back
Management:
- Educate the family
- Hold the baby
- Call the police
- Call social workers
Child Stair Gate

Uses:
- Falls prevention
Car Seat

Question: Does car seat use prevent disability?
Answer:
-
Yes, by preventing head & body injury
-
Holds the child down
-
Mandatory by law in many countries
-
Purpose: To prevent child trauma and disability.
-
Age <1 year: Seat should face opposite the driver (rear-facing).
-
Age <3 and >3: “Smle direction” chair (front vs. rear facing logic) used to prevent child trauma.
-
Stair Gate: Essential for accidental injury prevention.
-
diff etiology for stridor (Inspiratory)
- Angioneurotic oedema
- bacterial trachitis (Fever)
- croup (Fever)
- diphtheria (Fever)
- epiglotitis (Fever)
- foregin body
- hypoglycemia
ABCDEF-----H

6 month earlier between female and male kids
Giardia lamblia
Human Rota virus
schistosoma mansoni - terminal
schistosoma haematobium
Dust mite
pediculosis
Key Associations
| Finding | Diagnosis |
|---|---|
| C-shape calcification | CMV |
| Tram-track calcification | Toxoplasmosis |
| Salmon-colored rash | Systemic JRA |
| Blueberry muffin rash | CMV/Toxoplasmosis |
| Target lesion | Erythema multiforme |
| Strawberry tongue | Kawasaki |
| Port-wine stain | Sturge-Weber |
| Café-au-lait spots | NF type 1 |
| Frog position + tongue fasciculations | SMA type 1 |
| Scissoring + fisting | Spastic CP |
| Drooling + tripod position | Epiglottitis |
| Double bubble | Duodenal atresia |
| Boot shape heart | TOF |
| Egg on side/string | TGA |
| Snowman sign | TAPVD |
| Box shape heart | Ebstein anomaly |
Quick Reference: TORCH Infections
| Feature | CMV | Toxoplasmosis | Rubella | HSV |
|---|---|---|---|---|
| Calcification | Periventricular (C-shape) | Tram-track (border) | - | - |
| Rash | Blueberry muffin | - | - | Vesicular |
| Eye | Chorioretinitis | Chorioretinitis | Cataract | Keratoconjunctivitis |
| Hearing loss | + | - | + | - |
Notes on Cataracts (Leukocoria / White Reflex):
- Associated with Galactosemia (most common metabolic), Rubella, Congenital Glaucoma, CMV, Toxoplasmosis, or can be isolated. | IUGR | + | - | + | - |
Tilt Table Test

Technique:
- Tilt table test
- If drop in systolic >20, this is significant
Indications:
- Postural hypotension
- Diagnosis of vertigo
- Syncope
- Tachycardia with standing
Contraindications:
- Coma
- Severe anemia
- Severe heart failure
Valsalva Maneuver

Indications:
- Supraventricular tachycardia
- Decrease arterial refractory period
- Cases of syncope
Time:
- 5-10 seconds
Other Vagal Maneuvers:
- Vagal stimulation via closing the nose.
Erythema Multiforme




Scenario: Ill-looking 10-year-old boy with fever 38°C, purpuric rash widely distributed, appeared after starting antibiotic for otitis media
Q1: What is the name of skin lesion?
- Target lesion
Q2: What is the diagnosis?
- Erythema multiforme
differentials
- infection
- Herpes simplex
- mycoplasma
- phenoparbitol
Q3: How would you treat?
- ICU admission
- IV antibiotics
- Antihistamine
- IVIG
Complications? May develop into steven jhonson syndrome - mortality rate becomes 50%

Marginatum rheumatic fever


Erythema Marginatum

Rash? Erythema Marginatum.
Associated condition? Acute rheumatic fever.
Scabies



Scenario: A 9 month old infant presents with numerous excoriated, erythematous papules and pustules on the wrists, abdomen, periaxillary skin, ankles, and feet. Some of the lesions appear to be infected secondarily. The patient appears uncomfortable. Mother reports that her other children only have a few pruritic lesions. Mother denies any lesions but habitually rubs the interdigital webs of her hand
Diagnosis:
- Scabies
Symptom Severe itching, similar family symptoms, recent hike, scabies burrows
Findings?
Lymph node enlargement
Differential lymphoma until proven otherwise
infection, malignancy, congenital, …

Differentials: Phenytoin, leukemia, bad oral hygiene
Bone marrow of pediatric patient
Finding?
Visceral Leishmania donovani body


Other findings huge splenomegaly, privish
Lipid storage disease, foaming

owl’s eye appearance” refers to the distinct look of Reed-Sternberg (RS) cells, which are the hallmark diagnostic feature of Hodgkin lymphoma.

Ophthalmia Neonatorum


chlamydia inclusion bodies, on periphery of cells
Differentials
- Group B streptococcus <2wks
- Chalmydia >2wks
treatment Erythromycin for 2 weeks 3 times day
subconjuctival hemorrhage

Sudden bleeding differentials 1- Trauma (accident, nonaccidental) 2- platelet disorder (ITP, ..) 3- Coagulation (Factors, hemoph, christm) 4- Wall (vasculitis)
Occurs with
- Marfan syndrome
- homosynsatornoria not synsottonosis?


Colomboma

Papilledema
Increased intracranial pressure or Blood pressure





Findings
Chorioretinitis,
Differentials
- CMV
- Congenital Toxoplasmosis
Cherry red spot


Scenario VSD, did dental, didnt get antibiotics
Findings Roth spots



Phakomata, Tuberous sclerosis



Acute otitis media


Audiometry



| Type | Mechanism | Common Differentials |
|---|---|---|
| Conductive Hearing Loss | Problem conducting sound waves anywhere along the route through the outer ear, tympanic membrane (eardrum), or middle ear (ossicles). | - Acute Otitis Media (AOM) - Otitis Media with Effusion (Glue ear) - Impacted Cerumen (Earwax) - Foreign body in canal - Perforated tympanic membrane - Otosclerosis - Microtia/Atresia of the ear canal |
| Sensorineural Hearing Loss (SNHL) | Damage to the inner ear (cochlea) or to the nerve pathways from the inner ear to the brain (Cranial Nerve VIII). | - Congenital: CMV, Toxoplasmosis, Rubella (TORCH infections) - Genetic: Usher syndrome, Waardenburg syndrome - Acquired: Meningitis, Mumps, Ototoxic drugs (e.g., Gentamicin) - Noise-induced trauma - Perinatal hypoxia |
| Mixed Hearing Loss | A combination of conductive and sensorineural hearing loss (damage in both the outer/middle ear and the inner ear/nerve). | - Chronic Suppurative Otitis Media (causing both ossicular damage and toxic effects on the cochlea) - Temporal bone fractures - Certain congenital malformations - Otosclerosis involving the cochlea |



Findings
Erythema nodosum
Differentials
- TB,
- STEPT,
- IBD,
- SARCOIDISIS,
- FUNGAL INFECTIONS
- LEPROSY
Cutaneous leishmania (female sandfly)


Molluscum contagiosum


Slapped cheeks - parvovirus b19


Exnathema, gangrinomas - pseudomonas due bed ulcers…

Bruises
1- truama
2- platelet disorder
3- coagulation
4- vasculitis
bullae


Dystrophic Epidermolysis Bullosa

Respiratory System
Acute Epiglottitis
Scenario: 3 year old non-vaccinated boy presents with fever, worsening sore throat, and respiratory distress. Exam reveals toxic appearing child, temp 40°C, drooling of saliva, stridor and sitting in tripod position (trunk leaning forward, neck hyperextended, chin thrust forward).
Q1: What is likely diagnosis?
- Acute epiglottitis
- Finding: Thumb sign
Q2: How do you manage?
- Call the Anesthesia team and prepare for Endotracheal intubation
- First management: intubation and tracheostomy if failed
- All patients should be monitored in ICU
- IV Antibiotics
- Give Rifampin for close contacts
Causes: Staph most common (Streptococcus pneumoniae + Group A strept) if vaccinated, or Haemophilus influenzae type B if not vaccinated

Croup (Laryngotracheobronchitis)
Radiographic Sign: Steeple or pencil sign of the proximal trachea
Signs:
- Inspiratory stridor
- Barking cough
- Hoarseness
Causes:
- Parainfluenza virus type 1
- RSV
- Influenza virus
Management:
- Mild symptoms: Single dose of oral dexamethasone
- Moderate to severe symptoms:
- Supportive care: humidified air or oxygen, intravenous fluids
- Epinephrine
- Dexamethasone
- Surgical intervention if patient doesn’t improve

Pneumonia
X-Ray Finding: Consolidation
Q1: What is the diagnosis?
- Pneumonia
Q2: What is the causative organism?
- Streptococcus pneumoniae
Pneumothorax

Case: Tension pneumothorax, Right Side
Findings:
- Midline shift
- Lung collapse
- Decreased air entry
Treatment: Needle decompression
Asthma with Pneumothorax / Emphysema (CXR)

in This PIC Be Curfiat → Check Countage of the lung
Hint: Loss of contour of lung
- Check if hyperinflated
The hint is loss of Couture of lung in the emphysema → we doubt see?
Scenario: 5 year old with 3 days of acute asthma, progressive SOB, cyanosis.
CXR findings?
- Right-sided pneumothorax OR emphysema with left mediastinal shift
- Loss of lung opacity
- Other mentions in original: “Liver & mucus”, “Pneumonitis”
Management?
- Bronchodilator, inhaled steroid
- Suction + physiotherapy
- If pneumothorax: chest tube — 5th intercostal space, anterior axillary line
- Possible intubation
Cardiology
CXR Patterns
| Condition | Description |
|---|---|
| TGA (Transposition of Great Arteries) | Egg on side, generalized cardiomegaly, narrow mediastinum |
| VSD/AVSD | Cardiomegaly, increased pulmonary vascular markings (plethoric lung fields) |
| Ebstein Anomaly | Marked cardiomegaly extends wall to wall (Box Shape) |
| Tetralogy of Fallot | Boot shape heart with upward cardiac apex (RVH), concave PA segment, decreased pulmonary vascular markings |
| Total Anomalous Pulmonary Venous Drainage | Snowman or figure of 8 - dilated vertical vein on left + brachiocephalic vein on top + SVC on right form the head; enlarged atrium forms the body |
| Heart Failure | Nonspecific cardiomegaly |
Specific Images
TGA:

- Egg on string appearance - EGG ON SIDE, generalized cardiomegaly, Narrow mediastinum Description: Knee chest position (Squating position) to treat the episodes of TOF
Snowman Sign (TAPVD):
snowman or figure of 8 Dilated vertical vein on the left and bracocephalic vein on top + superior vena cava on the right form the head of snowman, the body of snowman is formed by the enlarged atrium
Dx: Total Anomalous Pulmonary venous Drainage
Ebstein Anomaly:
Description: marked cardiomegaly extend from wall to wall (Box Shape)
Dx: Ebstein Anomaly
Tetralogy of Fallot:
Description: Boot shape heart with upward cardiac apex due to Right ventricular hypertrophy and concave pulmonary artery segment and decrease pulmonary vascular marking at peripheral lung felid.
Dx: Tetralogy of Fallot
VSD/AVSD:
Description: cardiomegaly, increase pulmonary vascular markings (plethoric lung fields)
DDx : VSD, AVSD
Cardiomegaly (Heart Failure): (nonspecific)

Heart Failure with Pulmonary Edema:
Scenario: 3-month-old with heart failure, cyanotic and cardiac murmur
Findings:
- Small heart
- Pulmonary edema
Surgical Scar:
- Mid or central sternotomy scar - open heart surgeries (repair of septal defect or valve replacement)
ECG Interpretations
WPW (Wolff-Parkinson-White)


Signs:
- Delta wave (not always clear)
- Short PR interval
- Wide QRS
Complications:
- SVT
- Atrial fibrillation
- Ventricular fibrillation
Management:
- Observation (intermittent can end by itself)
- Medication
- Catheter ablation
Long QT Syndrome (Jervell-Nielsen-Lange)

ECG Findings:
- QTc >0.45 sec (more than ½ RR interval)
Can lead to:
- Severe VT
- Sudden death
Treatment:
- Pacemaker with defibrillator
Causes:
- Congenital: Primary
- Acquired: Hypocalcemia, hypoglycemia
- Drugs: Erythromycin, quinolones
Monomorphic VT Monomorphic ventricular tachycardia


Finding: Regular wide QRS with v tachycardia
Treatment:
- Stable: Amiodarone or lidocaine
- Low BP but pulse present: Cardioversion
- No pulse: Defibrillation
Defibrillation:
- High energy
- No need for sedation
- No need for synchronization
Give 2 causes:
- Myocardia ischemia
- Myocarditis
How to Manage:
- CCB
- BB
- Amiodarone
- Adenosine
- Cardioversion
- Pulseless: defibrillation
Polymorphic VT (Torsades de Pointes)

ECG Findings:
- Wide QRS + ↑HR
- Twisting around the line
Cases:
- Myocardial ischemia
- Hypokalemia
Management:
- MgSOâ‚„
- Cardioversion if in shock
Asystole

Management:
- Start CPR immediately (may give amiodarone)
- No shock (only give shock in case of V.fib or tachycardia)
- Cardiac massage
Type II Second Degree AV Block

ECG Findings:
- No progressive prolongation
- Intermittent non-conducting P wave
Causes:
- Rheumatic fever
- SLE
- Myocarditis
- Electrolyte disturbance (hypokalemia, hypocalcemia)
- CHD
Treatment:
- Treat underlying cause
- Pacemaker
First Degree Heart Block
ECG Findings:
- Fixed prolongation of PR interval
Causes:
- Rheumatic fever
- SLE
- Myocarditis
- Electrolyte disturbance
- CHD
Treatment:
- Treat underlying cause

Third Degree AV Block


ECG Findings:
- Complete A/V dissociation
Causes:
- MI in adults
- BB, digoxin, and CCB
- Neonatal SLE → Can cause any type of heart block Cases:
- Maternal SLE
- Viral myocarditis
- Rheumatic fever
- Coronary ischemia
- Surgery for CHD
- CHD
ECG Findings:
- Bradycardia
- Difference between atrial rate and ventricular rate
- Atrioventricular dissociation
Treatment:
- Pacemaker
Atrial Fibrillation

Findings:
- Small P waves with irregular rhythm
Management:
- Elective cardioversion
- Medications (Amiodarone, digoxin)
Causes:
- Mitral stenosis
- Hyperthyroidism
- Cardiomyopathies
- Myocarditis
- Medications
Atrial Flutter


Findings:
- Saw-toothed appearance
Management:
- Elective cardioversion
- Medications (Amiodarone, digoxin)
Paroxysmal SVT

Findings:
- Abnormal P waves
- Narrow QRS complex
- Small T waves
- ↑ HR
Management:
- Rapid heart rate → Beta Blockers
- If patient in shock: cardioversion
- If patient unstable: medications like adenosine, amiodarone
- If patient stable: carotid massage, valsalva maneuver, ice bags, cold shower
Ventricular Fibrillation

Treatment:
- ER:
- Still has pulse → Cardioversion
- No pulse → Defibrillation
- ICU:
- Amiodarone → IV Line
- ICU for any resone - Amidaron → IV Line in ICU PIR
Kawasaki Disease
Physical Findings:
- Strawberry tongue
- Bilateral conjunctival injection
- Mucosal changes
- Cervical lymphadenopathy
Complication:
- Coronary artery aneurysm
Differentiation from Hand-Foot-Mouth Disease:
- No strawberry tongue in HFMD
- Fever >5 days in Kawasaki vs 2 days in HFMD










VSD Case
Scenario: At 2-week checkup, a murmur is heard for the first time in an acyanotic well baby. Diagnosis of VSD with left-to-right shunt is made.
Q1: Is the family justified for being upset about not hearing murmur in newborn period?
- In newborn there is decreased pulmonary vascular resistance (no murmur), but after 4-6 weeks will increase and cause murmur
Q2: Is it possible that CHF will develop before next visit at 1 month?
- Yes, if it is large VSD
Q3: Is pulmonary hypertension likely to be present at this time?
- No
Kernicterus

Scenario: 5-day old full-term infant develops severe hyperbilirubinemia. Despite phototherapy and exchange transfusion, condition deteriorates.
Signs:
- Arching of back
- Extension of neck
- Increased tone of upper limb
- Opisthotonus Z
- Fisting
Diagnosis:
- Kernicterus
Causes:
- Hemolytic disease of the newborn
- Sepsis with DIC
- Prematurity
Complications:
- CP
- Encephalopathy
- Mental retardation
- Delayed milestones
Abdominal Wall Defects
Gastroschisis

Characteristics:
- Usually no long-term sequelae
- Treatment: Surgical repair
Omphalocele

Characteristics:
- Usually associated with other anomalies
- Treatment: Surgical repair
Multi-organ Failure

Scenario: 7-day-old infant C/S delivery due to severe fetal bradycardia. Delivered completely limp, offered prolonged resuscitation. Currently comatose, anuric, very high liver enzymes.
Diagnosis:
- Multi-organ failure because of birth asphyxia
Clues:
- C/S
- Bradycardia
Roseola Infantum

Scenario: Infant with high fever (39.4-40.6°C) lasting 2 days. After fever ended, rosy-pink rash appeared mostly on trunk, neck, and arms. Rash not itchy, lasted 2 days.
Diagnosis:
- Roseola infantum
Hand-Foot-Mouth Disease





Scenario: A 2 years old child presented with two days history of fever, malaise, abdominal pain. Mother brought him to medical attention today because of the appearance of this rash.
Diagnosis:
- Hand-foot-mouth disease
Cause:
- Coxsackievirus A16
Why not Kawasaki:
- No strawberry tongue
- Fever only 2 days (Kawasaki >5 days)
Mongolian Spot

Finding:
- Blue-black spot on buttocks
Diagnosis:
- Mongolian spot
Management:
- Assure the mother (benign)
Gum Hyperplasia

Causes:
- Poor oral hygiene
- Medications (cyclosporine, phenytoin)
Hirsutism

Causes:
- Cyclosporine
- Minoxidil (antihypertensive)
Bitot Spot (Vitamin A Deficiency)

Finding:
- Silvery and scaly area in the sclera
- Bitot spot
Cause:
- Vitamin A deficiency
Encholi’s Pigment

Gastroenterology
Duodenal Atresia


X-Ray Finding:
- Double bubble sign (should not see gas beyond the double bubbles)
- 1 bubble in stomach, 1 in 1st part of duodenum
Associated with:
- Down syndrome
Management:
- Duodenostomy
Hirschsprung Disease

describe x-ray
There is fecal impaction, transitional zone (dilated part proximally and constricted part distally)
Barium Enema Findings:
- Fecal impaction
- Transitional zone (dilated part proximally, constricted part distally)
- Narrow distal segment
- Dilated proximal segment
- Funnel-shaped dilatation at level of transitional zone
Causes:
- Absence of ganglion cells (aganglionic megacolon)
Presentations:
- Delayed passage of meconium
- Chronic constipation
- Toxic megacolon
- Signs of intestinal obstruction
Confirmation:
- Rectal biopsy
Management:
- Resuscitation, NPO and IV fluids
- Antibiotics
- Rectal tube, irrigation
- At age 6-12 months: resection of aganglionic segment and anastomosing (formal pull-through procedure)
Intussusception



- 18 Months old boy presented with crying and vomiting.
- A bloody stool was passed on the day of the imaging examinations.
Diagnosis? Ileocolic intussusception.
Investigation? Barium enema.
Sign?
- Cut-off sign in the middle
- Coiled spring appearance / spring sign
Etiology:
- Idiopathic
- Secondary to: HSP, intestinal polyps
Emergency:
- Type of obstruction
Treatment:
- NPO/IV fluids
- NGT aspiration
- IV antibiotics
- Hydrostatic reduction with Barium/air enema
- Laparotomy and resection if needed
Complications:
- Ischemia and necrosis
Necrotizing Colitis

History:
- Presented with renal failure, anemia, low platelets
DDx:
- SLE
- Hemolytic uremic syndrome
Chronic Constipation


Nephrology & Urology
Vesicoureteral Reflux (VUR)

History:
- Recurrent UTIs
Modality:
- MCUG (micturating cystourethrogram)
Findings:
- Posterior urethral valve
- Dilated ureters
- Tortuous ureters
- Dilated ureteric pelvis bilaterally (hydronephrosis)
Diagnosis & Grading
- Studies: Renal US (Typically first); MCUG (to confirm diagnosis); RNC (for follow-up).
International Grading System (MCUG Findings):
| Grade | Description / Findings |
|---|---|
| Grade I | Into a nondilated ureter only. |
| Grade II | Into the pelvis and calyces without dilation. |
| Grade III | Mild to moderate dilation of ureter, pelvis, and calyces; minimal blunting of fornices (become close). |
| Grade IV | Moderate ureteral tortuosity and dilation of pelvis and calyces (adhered to each other). |
| Grade V | Gross dilation; significant tortuosity; loss of papillary impressions; blunting of calyces. |


Risk Factors:
- Congenital
- Holding voiding
- Chronic constipation
- Recurrent UTI
Complications:
- Renal scarring
- Hypertension
- End-stage renal failure
Management:
- Antibiotic prophylaxis
- Surgery for grades 4-5

Posterior Urethral Valve (PUV)


Modality:
- MCUG / VCUG (voiding cystourethrogram) only in boys
Findings:
- Dilated proximal urethra
- Dilated ureter
- Dilated bladder
- Dilated posterior urethra
Only in boys
Can be diagnosed antenatal and prevented!
Complications:
- Renal failure
- UTI
Treatment:
- Surgical removal of the valve
- Catheter or drain procedure as temporary measure
Prune Belly Syndrome


Triad:
- Hydronephrosis
- Undescended testis
- Deficient abdominal musculature
Characteristics:
- Rare syndrome
- Sporadic, not inherited
- Exclusively occurs in boys
Bladder Exstrophy (Ectopia Vesicae)

Characteristics:
- Congenital anomaly with bladder outside abdomen
- Treatment: surgical
- Can lead to bladder dysfunction
Renal Stones

Best Investigation:
- Unenhanced spiral CT (most sensitive)
Bilateral Nephrocalcinosis

Plain X-ray:
- Bilateral nephrocalcinosis
Causes:
- Hypercalcemia → hypercalciuria
- Hyperparathyroidism
- Isolated hypercalciuria
- Bartter kidney disease
- Distal renal tubular acidosis
Renal Artery Stenosis

After angioplasty:
- Improvement in renal artery stenosis
Horseshoe Kidney
Characteristics:
- Make sure no other conditions
- More prone to trauma
- More liable for obstruction
Bilateral Renal Agenesis

Findings:
- Squashed face (oligohydramnios)
Prognosis:
- Not compatible with life
- Die usually due to pulmonary hypoplasia
Hypospadia
Findings:
- Abnormal opening in the urethra (ventral aspect)
Important:
- Circumcision is contraindicated because the foreskin will be used later to close the opening
- Surgical repair needed later
Chordee
Findings:
- Flexion deformity of the penis
- Due to contraction secondary to delayed hypospadia repair
Cast Types


| Type | Description | Indication |
|---|---|---|
| RBC Cast | Well demarcated | Glomerular disease |
| Granular Cast | Denatured RBCs | Renal tubular damage |
ITP (Immune Thrombocytopenic Purpura)

Q1: What is the only investigation that will help you?
- Platelet count
Q2: What is the serious complication?
- Intracranial hemorrhage
Iron Deficiency Anemia
Peripheral Blood Smear:
- Microcytic hypochromic RBCs
Q1: What is the possible cause?
- Iron deficiency
Q2: What is the treatment?
- Iron supplement
Perthes Disease

Diagnosis:
- Perthes disease (Legg-Calvé-Perthes disease)
Cause:
- Avascular necrosis of the femoral head
Most Common Cause of Limping in Children:
- Transient synovitis
Risk Factors:
- Sickle cell disease
Down Syndrome (Trisomy 21)


Eight-year-old boy with dysmorphic features and learning disability. She was operated for congenital heart disease at infancy.
Diagnosis? Down Syndrome.
Most common cause? Trisomy 21 (meiotic non-disjunction).
Which investigation helps in assessing this patient?
- Thyroid hormone levels
Describe facial features? Epicanthic fold, brush field spots in iris, strabismus, upslanted palpebral fissures
What is the most common Musculoskeletal Problems? Atlantoaxial instability
What are the long-term complications associated with Down Syndrome? Leukemia, hypothyroidism, and obesity.
Marfan Syndrome / Ehlers-Danlos Syndrome

Findings:
- Hypermobility of joints (hyperelasticity)
- Long fingers
Diaphragmatic Hernia


- Anterior diaphragmatic hernia
Meckel-Gruber Syndrome
Associated with:
- Occipital encephalocele
Occipital Encephalocele

Findings:
- Opening in skull → herniation of brain tissue
Important:
- Any midline swelling from base of nose to base of neck → Don’t send for surgical excision (might be encephalocele)
- Do CT scan to ensure no brain tissue
Part of:
- Meckel-Gruber syndrome

This patient presented with hypocalcemia
Most likely diagnosis? X Pseudohypoparathyrodism
Infectious Diseases
Bacterial Infections
Group B Streptococcus (GBS)


- Baby with severe resp distress after birth. Blood cluture shows gram +ve cocci
- Cause ?
- GBS
- 2nd picture shows ?
- Gram negative N.meningitides
Meningococcemia
,Parents bring their child in for evaluation due to acute development of high fever, malaise and lethargy. On exam, the patient is mottled with poor perfusion, tachycardic, and has developed a new rash
!
Findings:
- Purpura, petechiae, ecchymosis (non-blanching)
- Mottled appearance
- Poor perfusion
- Tachycardia
Blood Culture:
- Gram negative N. meningitidis
Diagnosis:
- Meningococcemia
Scenario: Baby with severe respiratory distress after birth
Blood Culture:
- Gram positive cocci
Cause:
- GBS
Tuberculin Skin Test
Route of injection:
- Intradermal
When positive:
- When there is 5mm induration in endemic area
Procedures & Devices
Intraosseous Infusion


Indications:
- Administration of fluids and medications
- Unacceptable IV line
- Patient in shock needing rapid access
Contraindications/Precautions:
- Infection at entry site (cellulitis)
- Osteogenesis imperfecta
- Fracture
- Severe bleeding
Procedure:
- After 2nd trial, change site
Peak Expiratory Flow Meter


- end Exisiotomy meter What it measures:
- FEV1 (Forced Expiratory Volume in 1 second)
Automated External Defibrillator (AED)

Uses:
- Cardioversion
- Defibrillation
- Pacing for ↓ HR
Indications:
- Pulseless ventricular tachycardia (VT)
- Ventricular fibrillation (VF)
- Cardiac arrest due to or resulting in VF
Contraindications:
- Dysrhythmias
- Multifocal atrial tachycardia
Error:
- Not making paddles closer (may shock self)

Peak Expiratory Flow Meter


- end Exisiotomy meter What it measures:
- FEV1 (Forced Expiratory Volume in 1 second)
Spirometry / Peak Expiratory Flow Meter


Device? Spirometry / Peak expiratory flow meter
What does it measure? PEF (Peak Expiratory Flow) / FEV1.
Aerochamber Spacer with Mask
Name:
- Aerochamber spacer with mask, flow valve and MDI
Age:
- With mask: 2-3 years
- With mouthpiece: 6-9 years
Indication:
- Bronchial asthma below 5 years
Advantages:
- Slows down medicine delivered from metered-dose inhaler
- Medicine stays in spacer for child to breathe into lungs
- Without spacer, medicine sprays directly into mouth/throat, less reaches lungs
Medications used:
- Bronchodilator
- Corticosteroid
Positive Pressure Ventilation (PPV)

Procedure:
- PPV by Ambu bag
IV Catheter Insertion

Type of insertion: Intravenous line placement

